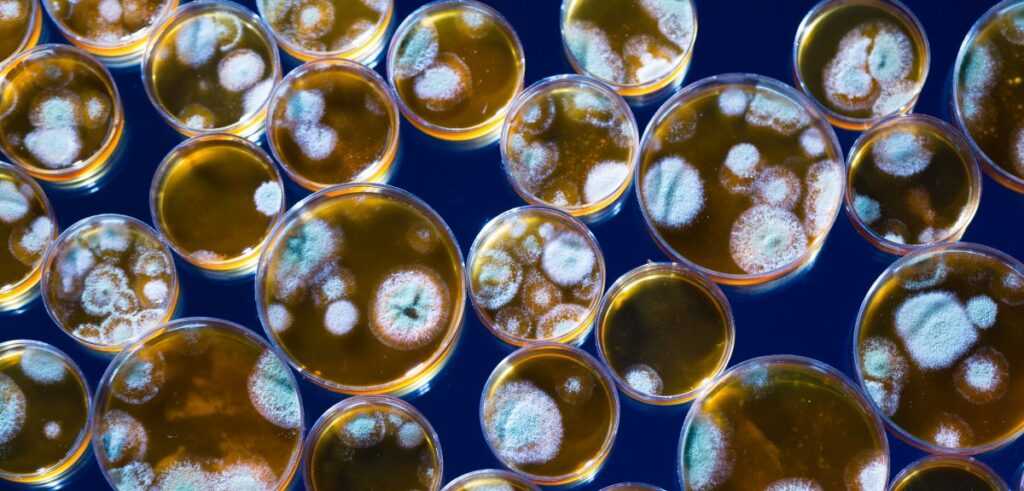
Антибіотики

Починаючи з 2015 року з ініціативи Всесвітньої організації охорони здоров'я в листопаді проводиться Всесвітній тиждень правильного використання антибіотиків (World Antibiotic Awareness Week).
Його мета — підвищити обізнаність людей про те, чому важливо вживати антибіотики лише для лікування хвороб, спричинених бактеріями, а також запобігати їх надмірному використанню.
Пропонуємо вам підвищити і власну обізнаність, а якщо інформація для вас вже відома - поділіться статтею із тими, кому це може бути цікаво!
В чому головна проблема, якщо коротко?
В даний час через антимікробну стійкість гине близько 700 000 осіб на рік. На думку експертів, якщо ситуація із застосуванням антибіотиків не зміниться, до 2050 року антимікробна резистентність стане причиною 10 мільйонів смертей щорічно і перевищить смертність від онкологічних захворювань.
А якщо антибіотики перестануть працювати, медицина фактично скотиться в середньовіччя.
Але в чому першопричина проблеми?
Що таке антибіотики?
Антибіотики, або протимікробні засоби - це речовини синтетичного або природного походження, які знищують мікроорганізми (бактерицидна дія) або пригнічують їх здатність до розмноження (бактеріостатична дія).
Відкриття Олександром Флемінгом в 1928 році першого антибіотика пеніциліну (це саме пеніцилін на фото вище) змінило подальший хід історії і розвиток медицини. Пеніцилін врятував життя багатьох людей під час Другої світової війни. А без антибіотиків багато процедур та оперативні втручання стали б більш небезпечнішими через підвищення загрози розвитку зараження крові.
З моменту відкриття антибіотиків ці препарати стали одним з найпотужніших засобів в арсеналі сучасної медицини.
Але є у антибіотиків і слабке місце...
Резистентність
Антибіотики ефективно нейтралізують багато видів бактерій, але не всі. Деякі види бактерій виробляють гени, які захищають їх від впливу ліків. Вони виживають при лікуванні і розмножуються, передаючи потомству ці свої гени, через що надалі ефективність медичних препаратів знижується.
А відтак лікувати хвороби стає складніше та довше. Хвороби дають ускладнення та призводять до інвалідності.
Крім того, може виникнути ланцюгова реакція. Адже не маючи дієвих антибіотиків, які можуть перемагати інфекції, дуже небезпечно проводити трансплантацію органів, хірургічні операції чи хіміотерапію під час онкологічних захворювань.
Зрештою антибіотикорезистентність бактерій робить лікування хвороб значно дорожчим, а це є додатковим тягарем на пацієнтів та платників податків. Наприклад, за даними ВООЗ вартість лікування одного пацієнта зі звичайним туберкульозом може становити близько 1 000$, а лікування одного пацієнта з хіміорезистентним туберкульозом —10 000$.

На цьому доволі відомому фото - результат посіву сечі на чутливість до антибіотиків, з якого випливає, що є інфекція - синьогнійна паличка, яка у даного пацієнта стійка до всіх антибіотиків і лікувати більше нічим...
Невже усе так погано?
Так, на жаль, стійкість до антибіотиків зростає до загрозливо високих рівнів у всьому світі.
Нові механізми стійкості з'являються і поширюються всюди, погрожуючи нашій здатності лікувати поширені інфекційні захворювання. Все більше інфекцій - наприклад пневмонію, туберкульоз, зараження крові, гонорею, захворювання харчового походження - стає важче, а іноді і неможливо лікувати через зниження ефективності антибіотиків.
Там, де антибіотики для лікування людей або тварин можна придбати без рецепта, виникнення і поширення стійкості поглиблюються. Аналогічним чином, в тих країнах, де немає стандартних лікувальних рекомендацій, антибіотики часто призначаються лікарями і ветеринарами надлишково і використовуються населенням понад міру.
За відсутності невідкладних заходів на нас почне насуватися пост-антибіотична ера, коли поширені інфекції і незначні травми знову можуть стати смертельними.

Що очікує нас у майбутньому?
В останній раз новий клас антибіотиків був розроблений 30 років тому. За цей час бактерії розвинули резистентність до всіх існуючих видів.
Виробництво антибіотиків - справа витратна, і від розробки до впровадження проходить чималий термін.
У 2017 році служба громадської охорони здоров'я Англії виступила з попередженням про те, що необхідно терміново вирішувати проблему стійкості до антибіотиків, інакше до 2050 року щорічно в світі вмиратимуть більше 10 000 000 осіб.
Стійкість до антибіотиків ставить під загрозу досягнення сучасної медицини.
За відсутності ефективних антибіотиків для профілактики і лікування інфекцій значно зросте ризик трансплантації органів, хіміотерапії та хірургічних операцій, наприклад кесаревого розтину.
Що саме робить бактерії стійкими до дії антибіотиків?
- Надмірне та нераціональне використання антибіотиків для лікування або профілактики хвороб. Особливо, шкідливо “лікувати” антибіотиками хвороби, спричинені, наприклад, вірусами.
- Недотримання курсу лікування. Переривання курсу лише робить бактерії сильнішими.
- Неякісний інфекційний контроль у медичних закладах.
- Недотримання базових правил гігієни та санітарії.
- Надмірне використання антибіотиків у тваринництві, розведенні риби та аграрних культур. Антибіотикорезистентні бактерії потрапляють в організм людини разом із їжею та водою.
- Відсутність принципово нових антибіотиків. Причина — надто швидка адаптація бактерій, що потребує оперативності та великих інвестицій.
Звісно, в боротьбі із резистентністю до антибіотиків дуже велику роль відіграють лікарі, фармацевтичні компанії, індустрія охорони здоров'я та політика МОЗ і держави вцілому.
Однак кожен громадянин окремо також впливає на ситуацію!

Що ви можете зробити вже зараз?
- Приймайте антибіотики тільки за призначенням кваліфікованого лікаря, жодних "подруга порекомендувала" чи "на форумі гарні відгуки";
- Ніколи не вимагайте антибіотиків, якщо, за словами медпрацівника, в них немає необхідності;
- Завжди слідуйте рекомендаціям при використанні антибіотиків, не закінчуйте курс за власним бажанням;
- Ніколи не давайте свої антибіотики іншим особам або не використовуйте ті антибіотики, що лишилися з попередніх призначень;
- Банально, але надзвичайно дієво: регулярно мийте руки, дотримуйтесь гігієни під час приготування їжі, уникайте тісного контакту з хворими і своєчасно робіть необхідні щеплення. Так ви зменшите шанси заразитися а, отже, зникне необхідність в лікуванні ;)

Антибіотики та COVID-19
Зловживання антибіотиками в період пандемії коронавірусу дуже сильно прискорить процес формування і поширення стійкості до протимікробних препаратів.
Варто пам'ятати, що збудником COVID-19 є вірус, а не бактерія, і тому антибіотики не слід використовувати для профілактики або лікування вірусних інфекцій, якщо вони не супроводжуються бактеріальним зараженням!
Кожен з нас може внести свій вклад в зниження резистентності до антибіотиків.
Дотримуйтесь нескладних правил, що описані вище, пильнуйте себе та будьте здорові!
P.S. Також не забувайте підписуватися на нашу групу у Telegram – t.me/TASlife, на нашу сторінку в Instagram, та на нашу сторінку у Facebook – facebook.com/taslifeofficial












